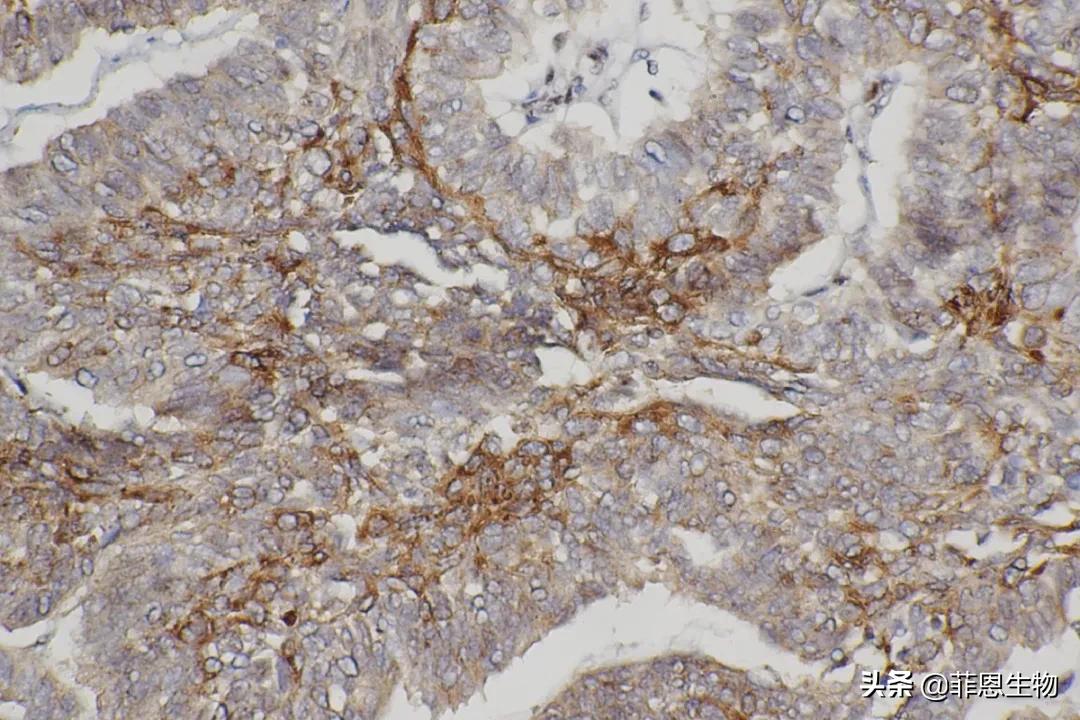
「技术分享」免疫组化基础（1）—如何标准化新免疫组化法

武汉菲恩生物科技有限公司品牌商
9 年
手机商铺
- NaN
- 0.2999999999999998
- 0.2999999999999998
- 2.3
- 2.3
推荐产品
公司新闻/正文
免疫组化基础(1)—如何标准化新免疫组化法
993 人阅读发布时间:2021-03-17 14:27
免疫组织化学(immunohistochemistry,IHCS)是用特异性抗体检测组织切片中抗原的一种方法。在鉴定蛋白质方面,IHC有着其他技术无法比拟的独特优点,可以将抗原检测与其在组织或细胞中的定位联系起来,这对于正常或病理组织的细胞功能研究具有重要意义。免疫组织化学,顾名思义,是将3个重要领域连接起来:形态学、组织化学和免疫学。我们重点介绍组织切片中抗原的检测,也会简单介绍细胞玻片的染色(这种情况应称为免疫细胞化学)。

方法学进化史
过去,免疫组织化学方法是使用荧光标记和冷冻切片。随着技术的进步,免疫组织化学已可被用于福尔马林固定的石蜡包埋组织切片,这就使得抗原检测能和形态学联系起来,并且可使存档的石蜡组织块得到使用。
在免疫组织化学方法中,抗体与组织中的抗原的结合通常是通过免疫组织化学染色反应来显示的。由于福尔马林固定可阻碍一些抗体对一些抗原的检测,目前已研发的许多“抗原修复”方法可以克服这个问题。反应的敏感性对于一些微量抗原的检测至关重要。
过去10年间,发展了许多高敏感性免疫组织化学方法。酶-底物-色原的不同组合可产生多种颜色,因此可以同时在一个切片上检测多种抗原。

标准化新免疫组化方法的一种实用方法
对一个新的免疫组织化学进行标准化是很困难的,因为有很多因素会影响结果。大部分市售抗体都只在人类组织中检测过而几乎没有在其他物种中检测过。抗体生产商的产品说明书对于抗体的使用非常重要,如其是否能检测某个物种的抗原、能否用于免疫组织化学方法检测Western blot方法所显示的抗原,以及能否检测冷冻切片中的抗原等。然而很多时候,这些信息无法得到,这就需要研究人员研发一种检测新抗体的标准化方法。下面介绍的研究方案是以福尔马林固定/石蜡包埋的组织块为研究材料。
方法
1、选取最有可能做阳性对照的组织,并最好包含已知的不表达待检抗原的毗邻组织。
2、对照组织的固定、包埋等过程与待检组织一致,并且应与待检组织来源于同一物种。如果有已知能与该抗体反应的其他物种组织,推荐设另外一组对照。
3、稀释一抗(通常1∶16稀释的抗体能很好地满足免疫组化染色)。
4、为了确定最佳的抗原修复方法(AR),需要准备三组玻片:第一组没有任何类型的抗原修复﹐第二组使用酶的抗原修复法(如蛋白酶K),第三组使用pH6.0的柠檬酸缓冲液的加热抗原修复法。
5、按照标准步骤进行免疫组织化学检测,根据已知抗体信息选择一抗孵育的时间和温度,如果没有已知信息,则室温下孵育60min。
6、IHC检测完毕后,观察玻片的染色效果。
注意事项
如果特异性染色成功后,需要进一步优化一抗的浓度,孵育时间、孵育温度﹑抗原修复方法等以使信噪比达到最优值。如果染色没有成功,就需要进一步调整一抗浓度﹑孵育的温度和时间(包括4℃过夜或者更长时间的孵育)、抗体修复方法(使用其他酶或者不同pH缓冲液)。
但需要注意的是,由于组织固定对抗原的影响、抗原的物种差异、抗体识别表位的缺乏或表达较低等因素,抗体最终可能仍检测不到抗原。



